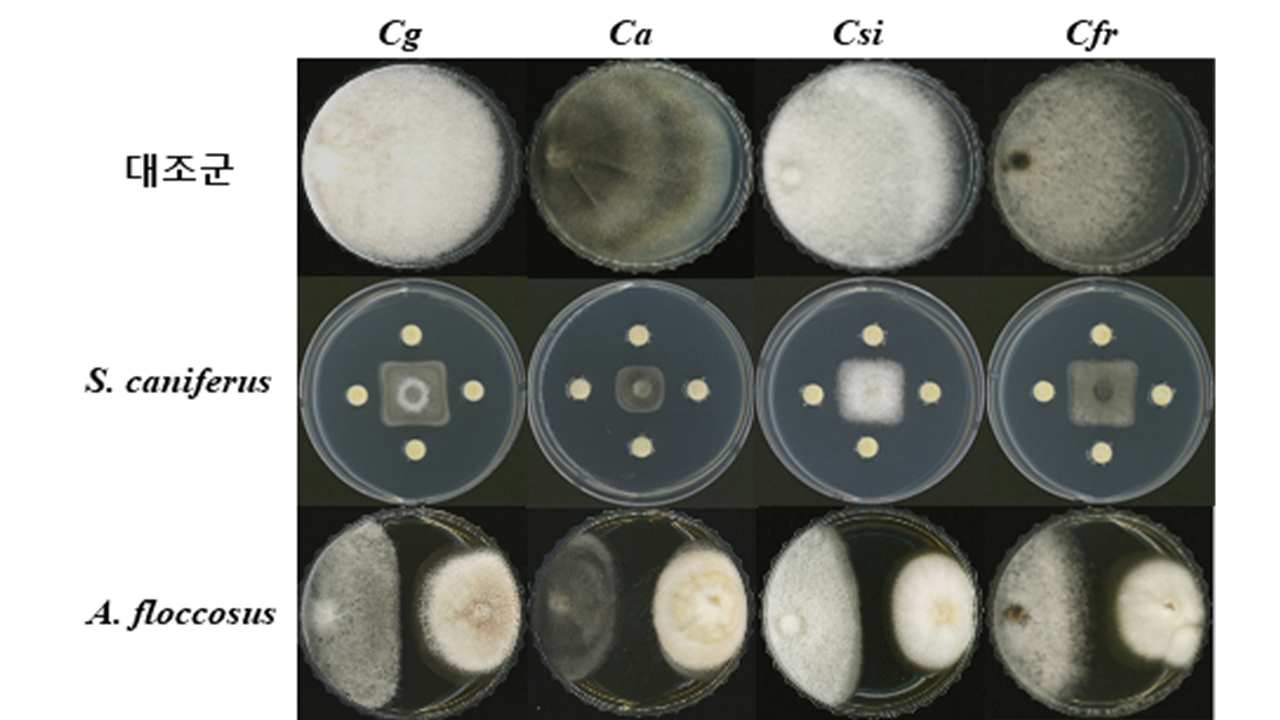
사진 제공 국립낙동강생물자원관

발견된 균주 2종은 과수 탄저병균에 균 효과를 보여 균사 생장을 70% 이상 억제하는 것으로 나타났습니다.
자원관 측은 해당 균주가 식물 생장 촉진 능력이 있는 것도 함께 입증했다며 특허를 출원할 예정이라고 밝혔습니다.
- # 낙동강생물자원관
- # 과수탄저병
- # 과일곰팡이병
- # 과수탄저병균
- # 향균
- # 과수탄저병억제
Copyright © Daegu Munhwa Broadcasting Corporation. All rights reserved.
안동포항 사회 대구MBC NEWS
김건엽 기자 입력 2025-10-24 12:13:41 조회수 3
발견된 균주 2종은 과수 탄저병균에 균 효과를 보여 균사 생장을 70% 이상 억제하는 것으로 나타났습니다.
자원관 측은 해당 균주가 식물 생장 촉진 능력이 있는 것도 함께 입증했다며 특허를 출원할 예정이라고 밝혔습니다.
Copyright © Daegu Munhwa Broadcasting Corporation. All rights reserved.